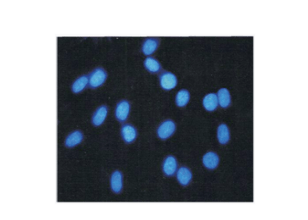

Unveiling Hoechst 33258 (Abbkine Catalog BMD0061): The Versatile Blue Fluorescent DNA Stain for Cutting-Edge Biological Research
In the fast-evolving realm of molecular biology and cell imaging, reliable high-performance DNA stains stand as cornerstones of impactful research—enabling breakthroughs in cell cycle analysis, apoptosis detection, and beyond. Among these essential tools, Hoechst 33258 from Abbkine (Catalog No.: BMD0061, Product Link: https://www.abbkine.com/?s_type=productsearch&s=BMD0061) has carved a niche as a trusted workhorse: a cell membrane-permeant, minor groove-binding blue fluorescent DNA stain that balances specificity, permeability, and brightness. What elevates it above competing reagents? Its unique mode of action, adaptability across experimental setups, and consistent performance make it indispensable for both routine lab work and pioneering investigations.
Central to the effectiveness of Abbkine’s Hoechst 33258 is its selective binding to the minor groove of double-stranded DNA (dsDNA), with a pronounced affinity for adenine-thymine (A-T) rich sequences. Unlike stains that require harsh fixation or permeabilization—steps that can disrupt cellular structure—this reagent seamlessly penetrates intact cell membranes, enabling live-cell imaging that captures DNA dynamics in real time without compromising cell viability. This capability is a game-changer for studies on cell proliferation, stem cell homeostasis, or drug-induced nuclear alterations. Excited at ~350 nm, it emits vivid blue fluorescence at ~460 nm, delivering an exceptional signal-to-noise ratio that minimizes background interference. Whether integrated into fluorescence microscopy, flow cytometry, or high-content screening workflows, its consistent performance ensures reproducible data—an essential prerequisite for rigorous scientific conclusions.
For researchers refining experimental design, Abbkine’s Hoechst 33258 (BMD0061) offers practical advantages that extend beyond its core specifications, with key insights to optimize results. A critical consideration is concentration-dependent binding: low concentrations (1-5 μg/mL) are ideal for live-cell studies to avoid cytotoxicity, while higher concentrations (10-20 μg/mL) enhance signal intensity for fixed-cell preparations. Its compatibility with a broad spectrum of fluorophores—including FITC, TRITC, and Alexa Fluor dyes—makes it a linchpin of multiplex imaging, facilitating co-localization studies of DNA with proteins, lipids, or other cellular targets. Proper storage is equally vital: maintaining the stain at -20°C in a dark environment preserves fluorescence stability, preventing photobleaching and extending its shelf life. Even with challenging sample types—adherent cells, suspension cultures, or tissue sections—its uniform staining pattern ensures comprehensive visualization of every cell in a population, eliminating gaps in data collection.
Beyond technical prowess, Abbkine’s dedication to quality and accessibility positions Hoechst 33258 (BMD0061) as a standout choice in the market. Priced at $29 for a 10 mg vial, it delivers exceptional value without sacrificing performance—a critical factor for labs balancing budget constraints with research excellence. Backed by Abbkine’s stringent quality control processes, each batch meets rigorous standards for purity and fluorescence efficiency, ensuring reliability across experiments. For early-career researchers, its straightforward protocol reduces the learning curve, while its robustness makes it a go-to for seasoned investigators tackling complex questions. From cancer cell metabolism and developmental biology to microbial genetics, its adaptability across disciplines underscores its role as a versatile tool that transcends research boundaries.
In an age where biological research demands precision, speed, and reproducibility, Abbkine’s Hoechst 33258 (Catalog BMD0061) exemplifies how a well-engineered reagent can accelerate scientific discovery. Its cell-permeant design, specific dsDNA binding, and bright blue fluorescence address core research needs, while multiplex compatibility and user-friendly protocols enhance its real-world utility. As the scientific community pushes the limits of cell biology and molecular imaging, tools like Hoechst 33258 remain indispensable—empowering researchers to visualize the unseen, quantify the elusive, and unravel the mechanisms driving life. For those seeking a reliable, high-performance DNA stain that delivers consistent results, Abbkine’s Hoechst 33258 (BMD0061) is more than a product; it is a catalyst for progress. Explore its full potential via the official product link and take your research to new frontiers.